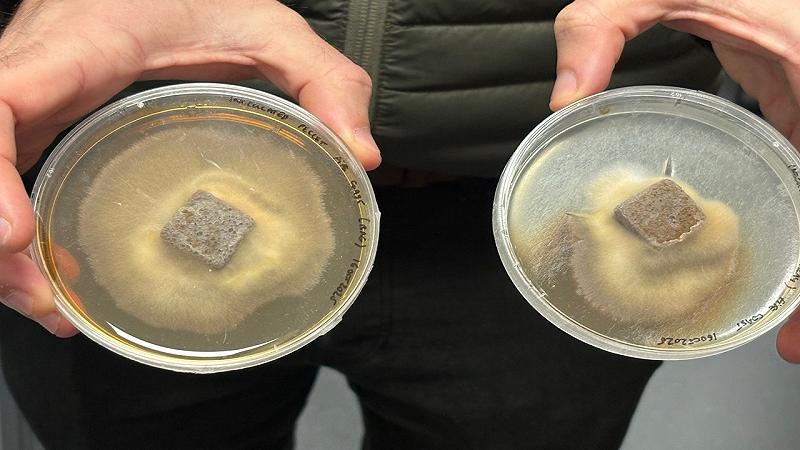
i piccoli pellet grigi rettangolari sono progettati per potenziare i progetti di piantagione di alberi in terreni in cui potrebbero mancare funghi vitali

Toby Parkes, fondatore di Rhizocore Technologies, è un ricercatore e inventore dei pellet ricavati da funghi che rigenerano le foreste. L’azienda scozzese realizza dei piccoli quadrati o rettangoli grigi da funghi micorrizici che vengono attaccati alle piantine seminate da poco.
I pellet rispondono alla mancanza di funghi nel suolo, importanti anche loro nella crescita degli alberi. La loro assenza indica deforestazione, agricoltura intensiva, attività umane prolungate. Gli alberi assorbono acqua e nutrienti dai funghi micorrizici, con i quali vivono una relazione simbiotica.
La Rhizocore sta costruendo vicino Edimburgo la più grande biblioteca vivente di funghi arborei al mondo. Esemplari di tutti i continenti per testare la possibilità di trasformarli in pellet. I ricercatori ne definiscono le condizioni ambientali e poi li coltivano. I funghi vengono poi trasformati in liquido applicabile ai pellet, la sopravvivenza degli alberi grazie a questa innovazione è aumentata fino al 25%.
Dalla Scozia al Nord America, per far crescere milioni di baby alberi dove l’uomo ha distrutto le loro condizioni per nascere, dalle brughiere ai campi agricoli abbandonati
Le parole di Toby Parkes in un’intervista: “I nostri risultati dimostrano chiaramente che il successo della semina può essere aumentato sfruttando i superpoteri di fertilizzazione sotterranea dei funghi. In genere i nostri clienti acquistano da noi i funghi che adattiamo alle loro condizioni, principalmente per motivi economici, volti a migliorare la sopravvivenza e il tasso di crescita degli alberi. A volte spavento il mio team, perché dico che vogliamo avere il più grande deposito vivente del pianeta, il che significherebbe 60.000 campioni. Vogliamo lavorare a livello globale e proteggere quante più specie fungine possibile, la biodiversità non si preoccupa dei confini”.
Rhizocore ha ricevuto un finanziamento di 4,5 milioni di sterline per espandere l’attività in Nord America, i costi della ricerca non sono pochi. Considerate che alcuni funghi vengono conservati in congelatore criogenico a una temperatura di -80°C. Come racconta Petra Guy, esperta di dati sulle piante dell’azienda, potrebbero contribuire alla rinascita di alberi in zone di brughiera, ex terreni agricoli o dove sono necessari interventi di riforestazione.
I funghi potenziano la crescita degli alberi in tutto il mondo è stato pubblicato per la prima volta su Lega Nerd. L’utilizzo dei testi contenuti su Lega Nerd è soggetto alla licenza Creative Commons Attribuzione-Non commerciale-Non opere derivate 2.5 Italia License. Altri articoli dello stesso autore: Daniela Giannace
